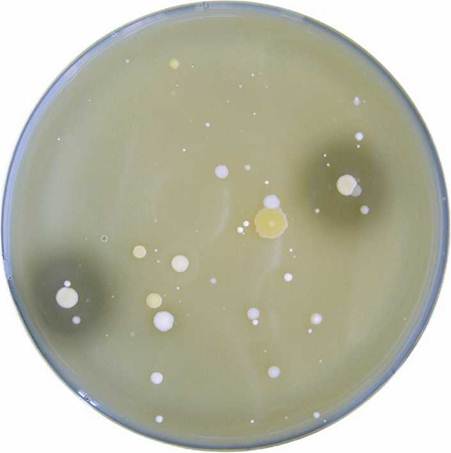

|
МЕЖГОСУДАРСТВЕННЫЙ
СОВЕТ ПО СТАНДАРТИЗАЦИИ, МЕТРОЛОГИИ И СЕРТИФИКАЦИИ |
|
|
МЕЖГОСУДАРСТВЕННЫЙ |
ГОСТ |
Методы определения солеустойчивых
микроорганизмов
|
|
Москва |
Цели, основные принципы и основной порядок проведения работ по межгосударственной стандартизации установлены ГОСТ 1.0-92 «Межгосударственная система стандартизации. Основные положения» и ГОСТ 1.2-2009 «Межгосударственная система стандартизации. Стандарты межгосударственные, правила и рекомендации по межгосударственной стандартизации. Правила разработки, принятия, применения, обновления и отмены»
Сведения о стандарте
1 РАЗРАБОТАН Федеральным государственным бюджетным научным учреждением «Всероссийский научно-исследовательский институт маслоделия и сыроделия» (ФГБНУ «ВНИИМС») и Федеральным государственным бюджетным научным учреждением «Всероссийский научно-исследовательский институт молочной промышленности» (ФГБНУ «ВНИМИ»)
2 ВНЕСЕН Федеральным агентством по техническому регулированию и метрологии (Росстандарт)
3 ПРИНЯТ Межгосударственным советом по стандартизации, метрологии и сертификации (протокол от 12 ноября 2015 г. № 82-П)
За принятие проголосовали:
|
Краткое наименование страны по |
Код страны по |
Сокращенное наименование |
|
Армения |
AM |
Минэкономики Республики Армения |
|
Казахстан |
KZ |
Госстандарт Республики Казахстан |
|
Киргизия |
KG |
Кыргызстандарт |
|
Россия |
RU |
Росстандарт |
4 Приказом Федерального агентства по техническому регулированию и метрологии от 8 декабря 2015 г. № 2118-ст межгосударственный стандарт ГОСТ 33568-2015 введен в действие в качестве национального стандарта Российской Федерации с 1 июля 2016 г.
5 ВВЕДЕН ВПЕРВЫЕ
Информация об изменениях к настоящему стандарту публикуется в ежегодном информационном указателе «Национальные стандарты», а текст изменений и поправок - в ежемесячном информационном указателе «Национальные стандарты». В случае пересмотра (замены) или отмены настоящего стандарта соответствующее уведомление будет опубликовано в ежемесячном информационном указателе «Национальные стандарты». Соответствующая информация, уведомление и тексты размещаются также в информационной системе общего пользования - на официальном сайте Федерального агентства по техническому регулированию и метрологии в сети Интернет
МЕЖГОСУДАРСТВЕННЫЙ СТАНДАРТ
МОЛОКО И МОЛОЧНАЯ ПРОДУКЦИЯ
Методы определения солеустойчивых микроорганизмов
Milk and dairy products.
Methods for determination of salt-tolerant bacteria
Дата введения - 2016-07-01
1 Область применения
Настоящий стандарт распространяется на молоко и молочную продукцию и устанавливает методы определения технически вредных солеустойчивых микроорганизмов, в том числе потенциально опасных для здоровья потребителей, стафилококков.
Методы применяются в условиях производственных лабораторий и дают возможность сделать вывод либо о безопасности продукции, либо о необходимости дальнейшего контроля продукта на предмет выявления коагулазоположительных стафилококков в специализированных лабораториях.
2 Нормативные ссылки
В настоящем стандарте использованы нормативные ссылки на следующие межгосударственные стандарты:
ГОСТ 12.1.004-91 Система стандартов безопасности труда. Пожарная безопасность. Общие требования
ГОСТ 12.1.019-791 Система стандартов безопасности труда. Электробезопасность. Общие требования и номенклатура видов защиты
__________
1 В Российской Федерации действует ГОСТ Р 12.1.019-2009 «Система стандартов безопасности труда. Электробезопасность. Общие требования и номенклатура видов защиты».
ГОСТ 12.4.009-83 Система стандартов безопасности труда. Пожарная техника для защиты объектов. Основные виды. Размещение и обслуживание
ГОСТ 12.4.021-75 Система стандартов безопасности труда. Системы вентиляционные. Общие требования
ГОСТ OIML R 76-1-2011 Государственная система обеспечения единства измерений. Весы неавтоматического действия. Часть 1. Метрологические и технические требования. Испытания
ГОСТ 177-88 Водорода перекись. Технические условия
ГОСТ 490-2006 Кислота молочная пищевая. Технические условия
ГОСТ 1770-74 (ИСО 1042-83, ИСО 4788-80) Посуда мерная лабораторная стеклянная. Цилиндры, мензурки, колбы, пробирки. Общие технические условия
ГОСТ 4233-77 Реактивы. Натрий хлористый. Технические условия
ГОСТ 4328-77 Реактивы. Натрия гидроокись. Технические условия
ГОСТ 5556-81 Вата медицинская гигроскопическая. Технические условия
ГОСТ 6709-72 Вода дистиллированная. Технические условия
ГОСТ 9284-75 Стекла предметные для микропрепаратов. Технические условия
ГОСТ ИСО 11133-1-2011 Микробиология пищевых продуктов и кормов для животных. Руководящие указания по приготовлению и производству культуральных сред. Часть 1. Общие руководящие указания по обеспечению качества приготовления культуральных сред в лаборатории
ГОСТ 12026-76 Бумага фильтровальная лабораторная. Технические условия
ГОСТ 13805-76 Пептон сухой ферментативный для бактериологических целей. Технические условия
ГОСТ 13928-84 Молоко и сливки заготовляемые. Правила приемки, методы отбора проб и подготовка их к анализу
ГОСТ 14919-83 Электроплиты, электроплитки и жарочные электрошкафы бытовые. Общие технические условия
ГОСТ 17206-96 Агар микробиологический. Технические условия
ГОСТ 19881-74 Анализаторы потенциометрические для контроля pH молока и молочных продуктов. Общие технические условия
ГОСТ 25336-82 Посуда и оборудование лабораторные стеклянные. Типы, основные параметры и размеры
ГОСТ 25706-83 Лупы. Типы, основные параметры. Общие технические требования
ГОСТ 26809.1-2014 Молоко и молочные продукты. Правила приемки, методы отбора и подготовка проб к анализу. Часть 1. Молоко, молочные и молочные составные, молокосодержащие продукты
ГОСТ 26809.2-2014 Молоко и молочная продукция. Правила приемки, отбор проб и подготовка их к анализу. Часть 2. Масло из коровьего молока, спреды, сыры и сырные продукты, плавленые сыры и плавленые сырные продукты
ГОСТ 27752-88 Часы электронно-механические кварцевые настольные, настенные и часы- будильники. Общие технические условия
ГОСТ 28498-90 Термометры жидкостные стеклянные. Общие технические требования. Методы испытаний.
ГОСТ 29169-91 (ИСО 648-77) Посуда лабораторная стеклянная. Пипетки с одной отметкой
ГОСТ 29227-91 (ИСО 835-1-81) Посуда лабораторная стеклянная. Пипетки градуированные. Часть 1. Общие требования
ГОСТ 31658-2012 Молоко обезжиренное - сырье. Технические условия
ГОСТ 32901-2014 Молоко и молочные продукты. Методы микробиологического анализа
Примечание - При пользовании настоящим стандартом целесообразно проверить действие ссылочных стандартов в информационной системе общего пользования - на официальном сайте Федерального агентства по техническому регулированию и метрологии в сети Интернет или по ежегодному информационному указателю «Национальные стандарты», который опубликован по состоянию на 1 января текущего года, и по выпускам ежемесячного информационного указателя «Национальные стандарты» за текущий год. Если ссылочный стандарт заменен (изменен), то при пользовании настоящим стандартом следует руководствоваться заменяющим (измененным) стандартом. Если ссылочный стандарт отменен без замены, то положение, в котором дана ссылка на него, применяется в части, не затрагивающей эту ссылку.
3 Термины и определения
В настоящем стандарте применены термины в соответствии с [1], а также следующий термин с соответствующим определением:
3.1 солеустойчивые микроорганизмы: Микроорганизмы, способные независимо от видовой принадлежности расти и развиваться в питательных средах массовой долей хлористого натрия более 7,0 % при температуре (37 ± 1) °С в течение 48 - 72 ч.
Примечание - Солеустойчивые микроорганизмы, являясь технически вредными микроорганизмами, могут включать в себя виды, потенциально опасные для здоровья потребителей.
4 Отбор проб
4.1 Отбор проб - по ГОСТ 32901.
Правила приемки и общие правила отбора проб - по ГОСТ 13928, ГОСТ 26809.1, ГОСТ 26809.2.
Пробы для микробиологических испытаний от продукции, попавшей в выборку, отбирают до отбора проб, предназначенных для органолептических и физико-химических анализов.
Отбор проб проводят в стерильную посуду достаточной вместимости и удобной формы (стеклянные колбы, банки, чашки Петри и т. д.), закрывают стерильными пробками или крышками, которые закрывают стерильной бумагой и обвязывают.
Отбор проб проводят с соблюдением вышеуказанных правил из точек, определенных программой производственного контроля, и в соответствии со схемами микробиологического контроля производства молочной продукции.
5 Метод определения общего количества солеустойчивых микроорганизмов
5.1 Сущность метода
Метод основан на способности солеустойчивых микроорганизмов, содержащихся в молоке и молочной продукции, независимо от их видовой и групповой принадлежности образовывать видимые колонии при посеве продукта либо его разведений на плотную питательную среду, содержащую 7,5 % хлористого натрия.
Большинство солеустойчивых микроорганизмов являются значимой микрофлорой порчи, а стафилококки - условно патогенными микроорганизмами. При выявлении солеустойчивых микроорганизмов в молоке и молочной продукции их видимые колонии могут образовывать микрококки, стафилококки, энтерококки и споровые аэробные палочки.
Из всех вышеперечисленных групп микроорганизмов наиболее солеустойчивые - стафилококки, для которых данный признак является родовым (обычно растут в присутствии 10 % - 15 % хлористого натрия).
Общеродовым признаком для микрококков является возможность роста в средах, содержащих до 5 % хлористого натрия; для энтерококков - до 6,5 % хлористого натрия; для споровых аэробов признак солеустойчивости внутри рода вариабелен. Для данных групп микроорганизмов возможность роста при 7,5 % хлористого натрия зависит от свойств конкретного штамма.
В сыроделии количество солеустойчивых микроорганизмов нормируют в рассолах, норма составляет не более 5 ∙ 104 КОЕ/см3.
Для молочных продуктов допустимым уровнем содержания солеустойчивых микроорганизмов, выявляемых данным методом, является норма не более 1 ∙ 104 КОЕ/см3.
5.2 Средства измерения, вспомогательное оборудование, материалы, посуда и реактивы
Анализаторы потенциометрические по ГОСТ 19881, типа I, с пределами допускаемого значения основной абсолютной погрешности преобразователя ± 0,02 ед. pH.
Весы неавтоматического действия по ГОСТ OIML R 76-1 с пределами допускаемой абсолютной погрешности ± 0,01 г.
Стерилизатор паровой медицинский (автоклав).
Баня водяная с обогревом, позволяющая поддерживать температуру от 0 °С до 100 °С, погрешностью ± 2 °С.
Термостат жидкостный, позволяющий поддерживать температуру от 15 °С до 55 °С, погрешностью ± 1 °С.
Термостат суховоздушный с естественной или принудительной циркуляцией воздуха или без нее, с охлаждением.
Термометр жидкостный стеклянный (не ртутный) по ГОСТ 28498, диапазоном измерения от 0 °С до 100 °С и ценой деления шкалы 1 °С.
Часы по ГОСТ 27752 или таймер.
Плитка электрическая по ГОСТ 14919.
Лупа по ГОСТ 25706, с кратностью увеличения от 4 до 10.
Емкости металлические или кастрюли, используемые для растворения, расплавления, нагревания или охлаждения питательных сред и воды.
Вата медицинская гигроскопическая по ГОСТ 5556.
Бумага индикаторная универсальная.
Бумага фильтровальная по ГОСТ 12026.
Пипетки 1-1(2)-1 по ГОСТ 29169.
Пипетки 1-1(2)-1(2)-1(2, 5, 10) по ГОСТ 29227.
Колбы мерные 2-50(100, 200, 500, 1000)-2 по ГОСТ 1770.
Колбы конические Кн-2-100(250)-34 ТХС по ГОСТ 25336.
Цилиндры 1(2)-50(100)-1 по ГОСТ 1770.
Пробирки П1(П2)-16-150 ТС по ГОСТ 25336.
Пробирки П1(П2)-21-200 ТС по ГОСТ 25336.
Чашки Петри ЧБН-1-100 или ЧБН-2 по ГОСТ 25336.
Стекла предметные для микропрепаратов по ГОСТ 9284.
Шпатель Дригальского.
Агар микробиологический по ГОСТ 17206.
Натрия гидроокись по ГОСТ 4328, растворы массовой долей от 20 % до 30 %.
Кислота молочная по ГОСТ 490, раствор объемной долей 20 %.
Натрий хлористый по ГОСТ 4233.
Водорода перекись по ГОСТ 177.
Пептон сухой ферментативный для бактериологических целей по ГОСТ 13805.
Автолизат дрожжевой сухой, массовой долей общего азота не менее 7,0 % и массовой долей аминного азота не менее 5,0 %.
Молоко гидролизованное сухое, массовой долей общего азота не менее 5,5 % и массовой долей аминного азота не менее 2,5 %.
Вода дистиллированная по ГОСТ 6709, соответствующая требованиям ГОСТ ИСО 11133-1 (подпункт 4.3.2).
Молоко коровье обезжиренное - сырье по ГОСТ 31658.
Допускается применение других средств измерения, вспомогательного оборудования, не уступающих вышеуказанным по метрологическим и техническим характеристикам и обеспечивающих необходимую точность измерения, а также реактивов и материалов по качеству не хуже вышеуказанных.
5.3 Подготовка к анализу
5.3.1 Приготовление питательной среды для определения солеустойчивых микроорганизмов
В качестве плотной питательной среды для выявления солеустойчивых микроорганизмов в молоке и молочной продукции используется молочно-солевой агар, состоящий из сухой питательной основы и обезжиренного молока.
5.3.1.1 Приготовление основы питательной среды
115.0 г сухой основы, включающей 23,0 г сухого гидролизованного молока либо сухого пептона, 75,0 г хлористого натрия, 2,0 сухого дрожжевого автолизата и 15,0 г агара, вносят в 1 дм3 дистиллированной воды. Смесь тщательно перемешивают, кипятят 3 - 5 мин до полного расплавления агара, не допуская пригорания. В полученной среде проверяют активную кислотность и, при необходимости, корректируют ее раствором гидроокиси натрия массовой долей от 20 % до 30 % или раствором молочной кислоты объемной долей 20 % до уровня (7,2 ± 0,1) ед. pH. Среду разливают в колбы, закрывают ватными пробками и стерилизуют при температуре (121 ± 2) °С в течение (20 ± 1) мин. Объем подготовленной основы питательной среды фиксируют для расчета дозы внесения стерильного обезжиренного молока.
5.3.1.2 Приготовление стерильного обезжиренного молока
Обезжиренное молоко разливают в пробирки или колбы (возможно использование 10 % восстановленного обезжиренного молока), закрывают ватными пробками и стерилизуют при температуре (121 ± 2) °С в течение (11 ± 1) мин.
5.4 Проведение анализа
5.4.1 Определение общего количества солеустойчивых микроорганизмов
Перед посевом основу питательной среды, подготовленную по 5.3.1.1, расплавляют на водяной бане либо в автоклаве в текучем паре в течение 20 - 25 мин и охлаждают до (45 ± 1) °С. К основе добавляют 10 % (по объему) стерильного обезжиренного молока, подготовленного по 5.3.1.2, хорошо перемешивают, соблюдая стерильность, разливают по 15 - 20 см3 в чашки Петри и ставят для застывания на горизонтальную поверхность. Застывшую среду подсушивают, так как ее влажная поверхность способствует слиянию колоний. Подсушивать среду в чашках Петри рекомендуется в термостате при температуре от 37 °С до 45 °С, расположив открытые чашки на стерильной бумаге в перевернутом виде. Время подсушивания - 1 ч. Допускается проводить подсушивание в боксе на столе при включенных бактерицидных лампах.
Срок хранения чашек с подготовленной средой, завернутых в стерильную бумагу, в холодильнике - не более 5 сут.
Объем (массу) засеваемого продукта или его разведения определяют исходя из предполагаемой обсемененности солеустойчивыми микроорганизмами. После тщательного перемешивания посевной материал, отобранный стерильной пипеткой в количестве 0,1; 0,2 или 0,5 см3, наносят на поверхность плотной питательной среды, обеспечивая тем самым аэробные условия для развития микроорганизмов. Профламбированным шпателем Дригальского посевной материал равномерно растирают по поверхности питательной среды.
Чашки Петри переворачивают крышками вниз и ставят в термостат с температурой (37 ± 1) °С на 48 - 72 ч.
Картина роста солеустойчивых микроорганизмов представлена в приложении А.
5.5 Обработка результатов
5.5.1 Подсчет общего количества солеустойчивых микроорганизмов
Каждую чашку переворачивают вверх дном и проводят подсчет количества выросших по 5.4.1 колоний, пользуясь лупой с кратностью увеличения от 4 до 10. Каждую подсчитанную колонию отмечают на дне чашки.
Общее количество солеустойчивых микроорганизмов X1, КОЕ/г(см3), вычисляют по формуле
|
X1 = n∙10m∙a, |
(1) |
где n - количество колоний, подсчитанных на чашке Петри;
m - число десятикратных разведений;
а - коэффициент пересчета, учитывающий объем посевного материала, вносимого в чашку Петри. При посеве 0,1 см3 коэффициент пересчета равняется 10; при посеве 0,2 см3 - 5; при посеве 0,5 см3 - 2.
За окончательный результат анализа принимают среднеарифметическое значение результатов, полученное по всем чашкам.
6 Метод выявления наличия/отсутствия стафилококков в нормируемых разведениях молочной продукции
6.1 В качестве условно-патогенных микроорганизмов в молочной продукции нормативным правовым актом [1] нормируется допустимое количество коагулазоположительных стафилококков в определенном объеме продукта.
В условиях производственных лабораторий допускается проведение оценки посевов нормируемых разведений продукта, выполненных в соответствии с 5.4.1, на наличие или отсутствие стафилококков.
В таблице 1 приведен перечень нормируемых по отсутствию стафилококков (S. aureus) продуктов с указанием объема (массы) продукта, в котором не допускается их наличие, а также перечень только тех молочных продуктов, в которых допустимая норма содержания стафилококков позволяет делать посев регламентируемого объема (массы) без предварительного обогащения.
|
Наименование продукта |
Объем (масса) |
Засеваемые |
|
|
Питьевое молоко, питьевые сливки, молочный напиток, молочная сыворотка, пахта, продукты на их основе, термически обработанные |
|||
|
Молоко питьевое, молочный напиток, в потребительской упаковке, в том числе обогащенные витаминами, макро- и микроэлементами, лактулозой, пребиотиками, пастеризованные |
1,0 |
0 |
|
|
Молоко питьевое, молочный напиток, во флягах, цистернах |
0,1 |
I |
|
|
Молочная сыворотка и пахта, в потребительской упаковке, пастеризованные |
1,0 |
0 |
|
|
Сливки и продукты на их основе, в том числе в потребительской упаковке: - пастеризованные |
1,0 |
0 |
|
|
- обогащенные |
1,0 |
0 |
|
|
- взбитые |
0,1 |
I |
|
|
Сливки и продукты на их основе, в том числе во флягах, цистернах |
0,1 |
I |
|
|
Продукты кисломолочные, продукты на их основе |
1,0 |
0 |
|
|
Термически обработанные сквашенные молочные и молочные составные продукты |
1,0 |
0 |
|
|
Творог, творожная масса, творожные продукты, продукты на их основе |
|||
|
Творог без компонентов (кроме произведенного с использованием ультрафильтрации, сепарирования, зерненного творога): - со сроком годности не более 72 ч |
0,1 |
I |
|
|
- со сроком годности более 72 ч |
0,1 |
I |
|
|
- замороженный |
0,1 |
I |
|
|
Творог, произведенный с использованием ультрафильтрации, сепарирования: |
|
|
|
|
- со сроком годности не более 72 ч |
0,1 |
I |
|
|
- со сроком годности более 72 ч |
0,1 |
I |
|
|
Творог зерненый |
0,1 |
I |
|
|
Творог с компонентами, творожная масса, сырки творожные: - со сроком годности не более 72 ч |
0,1 |
I |
|
|
- со сроком годности более 72 ч |
0,1 |
I |
|
|
- замороженные |
0,1 |
I |
|
|
Творожные продукты: - со сроком годности не более 72 ч |
0,1 |
I |
|
|
- со сроком годности более 72 ч |
0,1 |
I |
|
|
- замороженные |
0,1 |
I |
|
|
Альбумин молочный, продукты на его основе, кроме вырабатываемых путем сквашивания |
0,1 |
I |
|
|
Молоко, сливки, пахта, сыворотка, молочные продукты, молочные составные продукты на их основе, концентрированные и сгущенные стерилизованные, консервы молочные, молочные составные |
|||
|
Молоко сгущенное и концентрированное в транспортной упаковке, в том числе во флягах и цистернах |
0,1 |
I |
|
|
Сыры, сырные продукты: сверхтвердые, твердые, полутвердые, мягкие, плавленые, сывороточно-альбуминные, сухие; сырные пасты, соусы |
|||
|
Сыры, сырные продукты (сверхтвердые, твердые, полутвердые, мягкие, сывороточно-альбуминные): - без компонентов |
0,001 |
|
III |
|
- с компонентами |
0,001 |
III |
|
|
- копченые |
0,001 |
III |
|
|
Масло, паста масляная из коровьего молока, молочный жир, спреды |
|||
|
Масло из коровьего молока: сливочное (сладкосливочное, кислосливочное, соленое, несоленое) |
0,1 |
I |
|
|
Масло сухое |
0,1 |
I |
|
|
Паста масляная |
0,1 |
I |
|
|
Спред сливочно-растительный |
0,1 |
I |
|
6.2 Посев молочной продукции с целью выявления наличия стафилококков в нормируемом разведении проводят по 5.4.1, засевая параллельно две чашки по 0,5 см3 соответствующего разведения или продукта.
Для выявления наличия стафилококков в нормируемых разведениях необходимо:
- оценить колонии микроорганизмов, выросших на молочно-солевом агаре, и выделить колонии, характерные для стафилококков;
- проверить каталазную активность микроорганизмов, давших рост в виде характерных для стафилококов колоний;
- приготовить микропрепараты из характерных для стафилококков колоний.
6.3 Оценка колоний микроорганизмов, выросших на молочно-солевом агаре
На молочно-солевом агаре стафилококки образуют обычно поверхностные, круглые, среднего размера, блестящие, непрозрачные, непигментированные или пигментированные (золотисто-желтые, белые) колонии с ровным краем.
Для проведения оценки колоний на предмет их принадлежности к стафилококкам выбирают пять типичных колоний или все, если их количество на чашке меньше пяти.
6.4 Определение каталазной активности микроорганизмов, образующих колонии на поверхности плотной питательной среды
Выбранные колонии подвергают исследованию на каталазу.
Метод основан на способности каталазы, продуцируемой стафилококками при росте на питательной среде, разлагать перекись водорода с выделением пузырьков газа.
Кроме стафилококков, из перечня микроорганизмов, способных дать рост на молочно-солевом агаре, к каталазоположительным микроорганизмам относятся микрококки и споровые аэробные бактерии.
Колонии споровых аэробных бактерий, образуемые на молочно-солевом агаре (крупные, поверхностные, обычно белого или светло-кремового цвета, с неровным ползущим краем, чаще сухой складчатой поверхностью и концентрированным центром), легко отличаются от колоний стафилококков и микрококков.
Испытания проводят с охлажденной до комнатной температуры культурой, не допуская соприкосновения клеток с нагретой поверхностью и применяя обезжиренные предметные стекла и пипетки.
Для определения каталазной активности микроорганизмов, выросших на плотных питательных средах, на колонию, взятую с поверхности питательной среды и помещенную на предметное стекло, после выдержки на воздухе в течение 30 мин пипеткой наносят каплю 3 %-ного раствора перекиси водорода.
Допускается наносить перекись водорода непосредственно на поверхность колонии после приготовления микропрепарата.
При появлении пузырьков газа через 30 - 60 с считают, что они образовались в результате разложения перекиси водорода каталазой, образуемой микроорганизмами.
Вид колоний солеустойчивых микроорганизмов при определении каталазной активности приведен в приложении Б.
6.5 Микроскопирование колоний, характерных для стафилококков
Из выбранных колоний готовят микропрепараты по ГОСТ 32901 (подпункты 8.7.2.1 - 8.7.2.3).
Микропрепараты стафилококков отличаются от микропрепаратов микрококков по расположению клеток в поле зрения микроскопа. Стафилококки в микропрепаратах имеют форму кокков размером от 0,5 до 1,5 мкм и образуют неправильные скопления в виде виноградных гроздей, микрококки - одиночные, парные, тетрады, беспорядочные скопления кокков, размером от 0,5 до 3,5 мкм.
Микропрепараты стафилококков и микрококков приведены в приложении В.
Стафилококки присутствуют в нормированном разведении, если в посевах продукта или его разведений на молочно-солевом агаре присутствуют колонии, характерные для стафилококков согласно 6.3, имеющие положительный результат при проверке каталазной активности по 6.4, при микроскопировании которых наблюдается картина в соответствии с 6.5.
В случае отсутствия признаков роста стафилококков при посеве нормируемого разведения делается вывод о безопасности продукта по данному показателю.
В случае наличия стафилококков в нормируемом разведении необходимо провести контроль продукта на наличие коагулазоположительных стафилококков в аккредитованных лабораториях.
7 Требования безопасности
При выполнении работ необходимо соблюдать следующие требования:
- помещение лаборатории должно быть оборудовано общей приточи о-вытяжной вентиляцией в соответствии с ГОСТ 12.4.021;
- требования безопасности при работе в микробиологической лаборатории с микроорганизмами III - IV групп патогенности (опасности) в соответствии с положениями нормативного документа, действующего на территории государства, принявшего стандарт;
- требования техники безопасности при работе с электроустановками в соответствии с ГОСТ 12.1.019.
Помещение лаборатории должно соответствовать требованиям пожарной безопасности в соответствии с ГОСТ 12.1.004 и быть оснащено средствами пожаротушения в соответствии с ГОСТ 12.4.009.
Приложение А
(обязательное)
Картина роста солеустойчивых микроорганизмов
А.1 Картина роста солеустойчивых микроорганизмов приведена на рисунке А.1.
Рисунок А.1 - Вид колоний солеустойчивых микроорганизмов
Приложение Б
(обязательное)
Вид колоний солеустойчивых микроорганизмов при определении
каталазной активности
Б.1 Вид колоний солеустойчивых микроорганизмов при определении каталазной активности приведен на рисунке Б.1.
Рисунок
Б.1 - Вид колоний солеустойчивых микроорганизмов.
Реакция на каталазу - разложение перекиси водорода с выделением газа
Приложение В
(обязательное)
Микропрепараты стафилококков и микрококков
В.1 Микропрепараты стафилококков и микрококков приведены на рисунках В.1 и В.2.
Рисунок В.1 - Микропрепарат стафилококков
Рисунок В.2 - Микропрепарат микрококков
Библиография
|
Технический регламент Таможенного союза ТР ТС 033/2013 |
«О безопасности молока и молочной продукции» (принятый Решением Совета Евразийской Экономической комиссии от 9 октября 2013 г. № 67) |
Ключевые слова: молоко, продукция молочная, методы определения, солеустойчивые микроорганизмы, стафилококки, микроскопирование